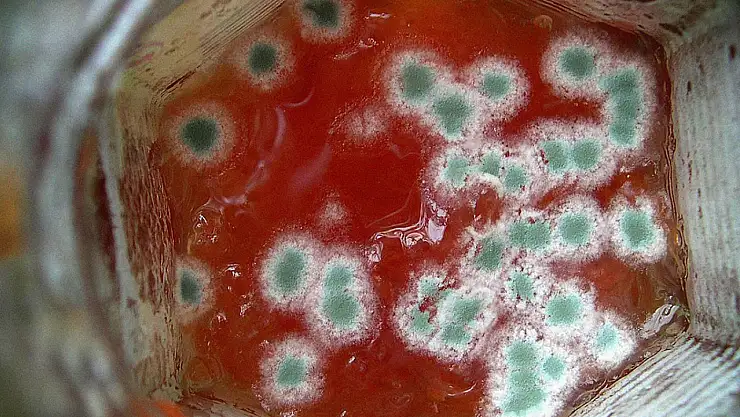
Tüm aşçıların uyguladığı sır. 1 damlası salçadaki küfü mıknatıs gibi çekiyor

Tüm aşçıların uyguladığı sır. 1 damlası salçadaki küfü mıknatıs gibi çekiyor
Salça, sofraların olmazsa olmazı bir besin. Şayet salçalarınız küfleniyorsa kesinlikle bu tüyoyu uygulayın. Tüm aşçılar salçadaki küf problemine karşı kavanoz kapağını tavsiye etti
Salça, domates veya biber gibi sebzelerin ezilerek kıvamlandırılmasıyla elde edilen bir sos çeşididir. Salça, yemeklere renk ve lezzet katmak için sıkça kullanılır. Ancak salça, hava ile temas ettiğinde küflenme riski taşır. Küf, salçanın tadını bozduğu gibi sağlığa da zararlıdır. Peki salçadaki küf sorunu nasıl giderilir? İşte
*Salçayı cam kavanozda saklayın. Cam kavanoz, plastik veya metal kaplara göre daha hijyenik ve hava geçirmezdir. Salçayı cam kavanoza aktarırken, kavanozun temiz ve kuru olduğundan emin olun.
*Salçanın üzerine sıvı yağ dökün. Sıvı yağ, salçanın hava ile temasını keserek küflenmeyi önler. Salçanın üzerine bir parmak kalınlığında sıvı yağ döktükten sonra, kavanozun ağzını sıkıca kapatın.
*Salçayı buzdolabında veya serin bir yerde saklayın. Sıcaklık ve nem, küf oluşumunu hızlandırır. Bu yüzden salçayı buzdolabında veya serin ve karanlık bir yerde saklamak, küflenmeyi geciktirir.
*Salçayı küçük porsiyonlara bölün. Salça her kullanıldığında hava ile temas eder ve küflenme riski artar. Bu yüzden salçayı ihtiyacınız kadar küçük porsiyonlara bölerek, tek seferde tüketebilirsiniz. Böylece salçanın geri kalanını daha uzun süre saklayabilirsiniz.
*Küflenen salçayı atın. Eğer salçada küf oluştuysa, ne yazık ki yapabileceğiniz bir şey yoktur. Küf, sadece yüzeyde değil, derinliklerde de yayılır ve salçanın tamamını etkiler. Bu yüzden küflenen salçayı atmak, en sağlıklı seçenektir.
SALÇADAKİ KÜFÜ YOK ETMEK İÇİN TERS ÇEVİRİN
Karamandan.com'da yer alan içeriğe göre, Biber pürenizi geniş bir tepside, zararlı maddelere maruz kalmayacak şekilde güneşin altında bekletin. İki günde bir tahta kaşıkla karıştırarak fazla suyunu çekmesini sağlayın. Bu yöntem güneşin sürekli olarak etkili olması gerektiğinden uzun sürebilir. - Suyunu çekmiş salçaları sıkıca kapanan bir kavanoza alın. Kavanoğun kapağını sıkıca kapatın ve ters çevirerek bir gece bekletin. Buzdolabında saklayacağınız salçanız bozulmadan muhafaza edilecektir.
Biber pürenizi derin bir tencereye alın ve suyunu çekene kadar kaynatın. Tahta kaşıkla karıştırarak dibi tutmamasını ve sıçrama olmamasını sağlayın. - Suyunu çektirdiğiniz biberleri sıcakken temiz kavanozlara dökün ve sıkıca kapatın. Kavanozları ters çevirerek bir gece bekletin. Buzdolabında saklayacağınız salça uzun süre tazeliğini koruyacaktır.
BİBER SALÇASI YAPARKEN DİKKAT ETMENİZ GEREKENLER
Biber salçası, Türk mutfağının vazgeçilmez lezzetlerinden biridir. Biber salçası yapmak için kırmızı biberleri yıkayıp, saplarını ve çekirdeklerini ayıkladıktan sonra, güneşte kurutmak gerekir. Kuruyan biberleri robotta çekip, tuz ve su ilave ederek, cam kavanozlara doldurun. Kavanozların ağzını sıkıca kapatın ve güneş gören bir yere koyun. Biber salçasının olgunlaşması için yaklaşık 40-50 gün bekleyin. Bu süre zarfında kavanozları ara sıra çalkalayın ve hava almasını sağlayın.
Biber salçası yaparken dikkat edilmesi gerekenler şunlardır:
- Biberleri seçerken, olgun, sağlam ve lekesiz olanları tercih edin. Çürük veya küflü biberler salçanın bozulmasına neden olabilir.
- Biberleri kuruturken, güneşli ve havadar bir yerde serin. Biberlerin üzerine sinek veya toz gelmemesine dikkat edin. Biberler tamamen kuruyana kadar bekleyin. Nemli biberler salçanın küflenmesine veya ekşimesine yol açabilir.
- Biberleri çekerken, robottan iyice geçirin ve püre haline getirin. Pürenin kıvamını su ile ayarlayabilirsiniz. Su miktarını azar azar ekleyin ve çok sulu olmamasına özen gösterin.
- Salçayı kavanozlara doldururken, kavanozların temiz ve kuru olmasına dikkat edin. Kavanozların ağzına kadar salça koymayın ve boşluk bırakın. Salça fermantasyon sırasında köpürebilir ve taşabilir.
- Salçayı olgunlaştırırken, güneş gören bir yerde saklayın. Kavanozları ara sıra çalkalayın ve hava almasını sağlayın. Salçanın üzerinde beyaz bir tabaka oluşursa, bu normaldir ve mayalanmanın işareti olarak kabul edilir. Bu tabakayı kaşıkla alabilirsiniz. Eğer salçanın üzerinde küf veya yeşillik oluşursa, bu salçanın bozulduğu anlamına gelir ve tüketmemelisiniz.
DOMATESİ BÖYLE SAKLAYIN Kİ BOZULMASIN
Komilizeytinyagi.com.tr'de yer alan bilgiye göre; Soslara katabileceğiniz domates püresini buzlukta saklamak için şu yöntemi uygulayabilirsiniz:
Domatesi rendelemek yerine blenderdan geçirecekseniz öncelikle kabuklarını soyabilirsiniz. Böylece soslarda kabuklar pütür halinde görünmez. Kabukları kolay bir şekilde soymak için öncelikle domatesleri kaynayan suya koyun ve yaklaşık 2-3 dakika bekletin. Bir maşa yardımıyla aldığınız domatesleri soğuk suya koyun. Soğuyan domateslerin kabuklarını artık kolaylıkla soyabilirsiniz.
Domatesleri blender yardımı ile püre haline getirin. Püre domatesi bir buzdolabı poşetinin içine döküp poşeti düzleştirerek buzluğa kaldırabilirsiniz.
Püf Noktası: Daha küçük porsiyonlar halinde kullanabilmek için domates püresini bulyon poşetine ya da buz kalıbına koyabilirsiniz. Buz kalıbına koyduğunuz domatesleri donduktan sonra çıkarıp buzdolabı poşetine koyabilirsiniz. Böylece hem birbirlerine yapışmaz hem de dondurucuda fazla yer kaplamaz.
Kaynak: Komilizeytinyagi.com.tr, Karamandan.com Derleme: Hakimiyet.com**